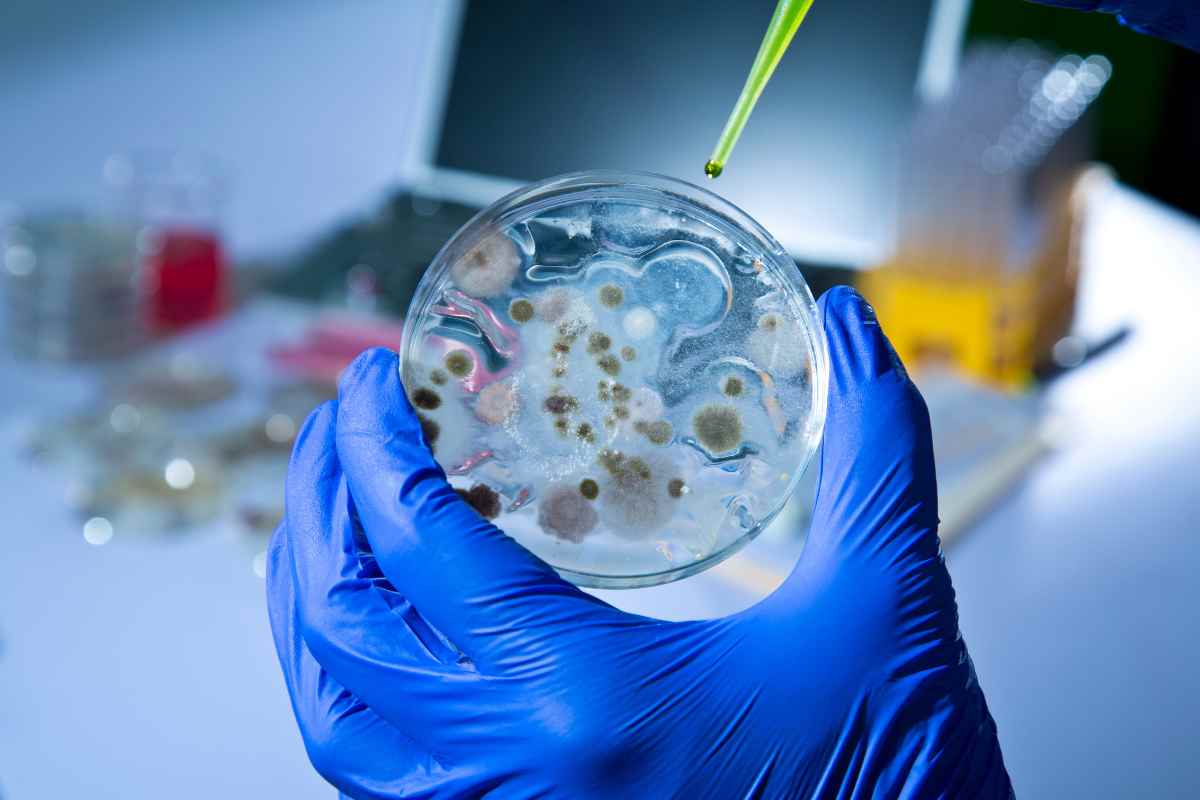
Allarme mondiale, 304 milioni di infetti e un milione di morti, di che si tratta

Allarme mondiale per questa infezione che sta causando un milione di morti: ecco di che si tratta, tutti i dettagli
Un allarme globale si sta diffondendo riguardo alla diffusione incontrollata delle epatiti virali, che colpiscono attualmente oltre 304 milioni di persone con infezione cronica nel mondo. I dati più recenti indicano che ogni anno si registrano circa 1,3 milioni di morti correlate a queste malattie, segnando un’emergenza sanitaria di portata planetaria.
Secondo gli ultimi rapporti pubblicati, la prevalenza delle infezioni croniche da epatite B e C rimane estremamente elevata, nonostante i progressi medici e le campagne di prevenzione. L’Organizzazione Mondiale della Sanità (OMS) stima che attualmente 304 milioni di individui convivano con un’infezione cronica, con un impatto devastante sulla salute pubblica globale. Le epatiti rappresentano una delle principali cause di cirrosi epatica e carcinoma epatocellulare, patologie spesso fatali se non diagnosticate e trattate tempestivamente.
Il bilancio delle vittime causate dalle complicanze epatiche ammonta a circa 1,3 milioni di decessi annuali, un numero che supera persino quello di molte altre malattie infettive di rilievo. Tra queste, l’epatite C, pur essendo curabile con antivirali ad azione diretta, continua a essere sottodiagnosticata, mentre l’epatite B, che si può prevenire con la vaccinazione, mantiene un’ampia diffusione soprattutto nei Paesi a basso e medio reddito.
Strategie di prevenzione e sfide attuali
Le campagne di vaccinazione contro l’epatite B e i programmi di screening mirati sono strumenti fondamentali per contenere l’epidemia, ma permangono significative difficoltà nell’accesso ai servizi sanitari, soprattutto in aree rurali e in Paesi con sistemi sanitari fragili. Inoltre, la mancanza di consapevolezza e di diagnosi precoce rappresenta un ostacolo cruciale per la riduzione della morbilità e mortalità legata alle epatiti.
Allarme mondiale, 304 milioni di infetti e un milione di morti, di che si tratta- roadtvitalia.it
Le strategie globali mirano a raggiungere l’eliminazione delle epatiti virali come minaccia per la salute pubblica entro il 2030, ma per centrare questo obiettivo è necessario intensificare gli investimenti in screening, trattamento e vaccinazione. La disponibilità di farmaci antivirali innovativi ha rivoluzionato la gestione dell’epatite C, ma resta indispensabile ampliare l’accesso a questi trattamenti per i pazienti più vulnerabili.
Oltre all’aspetto sanitario, le epatiti croniche comportano un rilevante impatto economico, dovuto ai costi associati alla gestione delle complicanze e alla perdita di produttività. La crescente incidenza di casi rende urgente l’adozione di politiche sanitarie coordinate a livello internazionale, con un focus particolare sulla prevenzione primaria e sull’educazione sanitaria.
L’attenzione mondiale si concentra ora su un approccio integrato che coinvolga governi, istituzioni sanitarie e società civile per contrastare questa epidemia silenziosa ma letale, che continua a mietere vittime in ogni continente. La sfida è lanciata: fermare la diffusione delle epatiti per salvare milioni di vite e contenere il peso socio-sanitario globale.

 Allarme mondiale, 304 milioni di infetti e un milione di morti- roadtvitalia.it
Allarme mondiale, 304 milioni di infetti e un milione di morti- roadtvitalia.it











